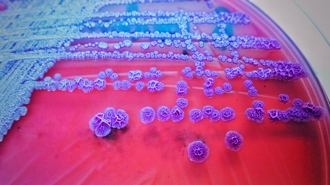
高雄一周爆6例類鼻疽釀2死 累計27例創史上新高

搜尋結果
以下是含有11例的搜尋結果,共96筆
-
流感未下降 單周10死75重症創高
本土流感疫情首見下降,疾管署14日公布,上周國內類流感門急診就診人次有13.7萬人,較前一周下降10.2%,不過重症數新增75例,創今年最高,死亡則新增10例。疾管署發言人曾淑慧分析,降溫主要受連假醫療院所休診所致,目前流感仍處流行高點,不能掉以輕心,並宣布加購20萬劑的公費流感疫苗。
-
高雄32歲女染本土登革熱 疑與同公司菲律賓境外移入個案有關
疾管署公布國內上周新增1例本土登革熱病例,為高雄市楠梓區一名32歲女性,目前染感源不明,不過經比對,和同公司不同樓層的一名同事,先前菲律賓境外移入個案,其基因序列完全相同,疾管署發言人曾淑慧表示,衛生局已經採取防治作為,擴大採檢500多名個案。目前還是流行季節,民眾應落實孳生源清除。
-
流感疫苗開打 嘉南湧排隊人潮
嘉義縣市、台南市1日開打公費流感疫苗及新冠疫苗。嘉縣開設407個社區接種站,80家合約院所於連續假日加開門診;嘉市開設90個社區接種站、83家醫療院所可接種;台南市準備超過50萬劑流感疫苗,404家合約醫療院所、37區衛生所同步開打,衛生所首日湧現排隊打疫苗人潮,打氣熱絡。
-
公費流感疫苗開打!嘉市自購1500劑供警員、教職員施打
嘉義縣、嘉義市1日都開打公費流感疫苗,嘉縣共開設407個社區接種站,80家合約院所於連續假日加開門診;嘉義市開設90個社區接種站、83家醫療院所都可接種,第一階段接種65歲以上長者、55歲以上原住民等族群,11月1日第二階段接種50至64歲者。
-
南投流感54例重症11死 高風險族群速接種疫苗
台灣流感疫情升溫,南投縣政府採購13萬7000劑流感疫苗,各地衛生所一早就湧進大批長輩排隊施打,副縣長王瑞德也帶頭接種「左流右新」,強調縣內有54例因流感併發重症住院,其中11例不治,死亡率20.3%,籲高風險族群盡快接種提升保護力。
-
百日咳累計44例創10年新高 1月大男嬰確診住院3周
疾管署今(9)日公布國內新增3例百日咳確定病例,為北部一起家庭群聚,指標個案為1個月大男嬰,因為食慾下降、尿量減少、呼吸急促就醫,因血氧太低,治療3周都尚未出院,其母親與未滿一歲的姊姊也都確診。疾管署表示,今年至今已經累計44例個案,創下2016年以來,十年來最高。
-
登革熱來襲!台南開出1110張罰單 最易滋生病媒蚊場域曝
目前正值登革熱病媒蚊孳生高原期,高雄累計12例本土登革熱群聚疫情,台南市登革熱防治中心綿密防堵疫情,截至9月8日累計開立舉發通知書1110件,其中最大宗陽性場域是住家,占了69%,其次為空地15%,孳生病媒蚊幼蟲容器態樣為「桶、缸、甕、盆」占49%最多,登防中心呼籲,如查獲孳生源即依規定開立舉發單,處3000元以上、1萬5000元罰鍰,且無改善期。
-
《興櫃股》安特羅、基米攜手捐疫苗 守護孩童開學健康
腸病毒感染對孩童是不可忽視的健康威脅,趁開學前夕,安特羅(6564)今(22)與基米(4195)共同捐贈安特羅腸病毒71型疫苗給忠義社會福利事業基金會的忠義育幼院,並由內湖誠康、瑞康、麗康診所總院長楊明達醫師協助到院施打,一起守護孩童健康。
-
時論廣場》屈公病來襲 強化登革熱預警系統(金傳春、黃基森、詹大千、蔡坤憲)
由於全球暖化、極端氣候及民眾疏於定期清除病媒孳生源,近兩年登革熱疫情在南美洲愈演愈烈,而傳播登革病毒的斑蚊今年在中國大陸、肯亞、巴西、波利維亞、阿根廷、祕魯、印度、斯里蘭卡、巴基斯坦、法屬馬約特島(Mayotte)、義大利、肯亞、模里西斯共和國等國均造成屈公病的疫情,其中中國廣東的病例數上升快,促全球衛生官員上緊發條防疫。
-
丹娜絲貽害 中南部傳染病齊發
近期受豪雨影響,全國各地多處積水、淹水,各傳染病齊發。疾管署5日公布,上周國內新增3例類鼻疽本土病例,均為丹娜絲颱風後發病,分別為高雄市2例、台中市1例;丹娜絲颱風後,國內也新增4例鉤端螺旋體病本土病例,今年已累計19例。
-
丹娜絲颱風後類鼻疽、鉤端螺旋體病增 防疫3步驟必看
近期受豪雨影響,造成各地多處積水、淹水,疾管署今日公布,國內上周新增3例類鼻疽本土病例,均為丹娜絲颱風後發病,分別為高雄市2例、台中市1例,個案年齡介於50至60多歲;另丹娜絲颱風後,國內新增4例鉤端螺旋體病本土病例,今年已累計19例。
-
腸病毒燒至8月底 大雨類鼻疽增4例
新生兒殺手,腸病毒伊科病毒11型要延長流行到8月底了!疾管署原本預估7月底就會脫離流行,但上周再增1例重症及1例死亡案例,兩名均為出生4天大的男嬰,死亡的中部男嬰出生後就呼吸窘迫,頻繁呼吸停止,隔天就不幸死亡,疫調發現其母親生產前一周就出現發燒症狀。
-
嬰兒染腸病毒出生4天亡 母產前曾發燒 疾管署:恐流行至8月底
新生兒殺手,腸病毒伊科病毒11型要延長流行到八月底了!疾管署原本預估七月底就會脫離流行,但上周再度新增1例重症1例死亡案例,兩名均為出生4天大的男嬰,死亡的中部男嬰出生後就呼吸窘迫,頻繁呼吸停止,隔天就不幸死亡,疫調發現其母親生產前一周就出現發燒症狀。羅一鈞預估,新生兒腸病毒流行將延長到8月底,呼籲家長和新生兒照護機構加強防範。
-
高雄一周爆6例類鼻疽釀2死 累計27例創史上新高
這次丹娜絲颱風不僅重創中南部,每逢颱風後,就會出現類鼻疽疫情,疾管署公布,上周高雄一口氣出現6例,創下歷年單周次高,且其中2例死亡,個案分別都有慢性肝病和高血壓病史,且有污水、污泥接觸史。疾管署統計,今年已經累計27例,創下23年來,有史以來同期最高紀錄。
-
侵襲新生兒 腸病毒伊科11型增2死
新生兒腸病毒拉警報!上周新增2死亡、1重症,均感染新生兒頭號殺手伊科病毒11型,今年已累計7例重症,4例死亡,創6年來最高。疾管署發言人羅一鈞表示,腸病毒重演7年前「兒童尚未流行,卻僅侵襲出生未滿一個月的新生兒」,疾管署17日 成立「應變工作小組」,呼籲即起至7月底都是流行期,產婦和新生兒應全面謝絕訪客,以免傳染。
-
赴非旅遊不知是瘧疾疫區!3男染重症 1人插管洗腎搶命
疾管署今(17)日公布國內新增3例境外移入瘧疾病例,為年齡介於40多歲至50多歲本國籍男性,4月下旬至5月下旬期間分別有貝南、肯亞旅遊史,返台之後陸續出現發燒、畏寒等症狀,經診斷均為惡性瘧重症個案,疾管署疫調發現,其中赴東非自助旅行的2人竟然不曉得非洲是疫區、未購買瘧疾預防藥物。今年瘧疾已累積11例,創19年來最嚴重,疾管署提醒,國人漸有自助遊非洲風潮,呼籲行前務必購買並服用瘧疾預防投藥,勿省錢因小失大感染瘧疾恐喪命。
-
屈公病境外移入創18年新高!登革熱上周增2例 均來自印尼
疾管署公布,屈公病今年累計11例,創18年來新高,均為境外移入並以印尼9例最多;登革熱國內上周新增2例境外移入,也均來自印尼,今年已累計44例,創5年同期次高。疾管署提醒,屈公病重症高風險群為新生兒、年長者、慢性病患者,民眾赴東南亞和南亞旅遊應注意防蚊。
-
北巿20多歲女赴越南旅遊染麻疹 傳給同事 接觸者達235人
疾管署今日(22)公布雙北麻疹群聚案,國內上周新增2例麻疹個案,其中1例為越南境外移入,是一名台北市20多歲女,3月底曾至越南旅遊;另1例為該案職場接觸者,為新北市30多歲女,研判為本土個案。兩案匡列共235名接觸者,須監測至5月11日。
-
麻疹、百日咳疫情雙創6年新高「禍首是這國」病例暴增21倍
越南近年來成為台灣人的熱門旅遊國家之一,據疾管署資料,台灣2025年至今的百日咳、麻疹疫情雙雙創下6年新高紀錄,許多案例正是來自越南,其中越南的百日咳案例甚至暴增21倍,相當驚人!由於百日咳、麻疹的高風險族群皆是嬰幼童,專家也呼籲家長最好先帶孩子接種疫苗再前往越南遊玩。
-
腸病毒升溫 1歲男童發病6天亡
疾管署2日公布,國內新增今年腸病毒第3起死亡案例,為南部1歲多男童,發病6天即不治,確診型別為克沙奇B5病毒。疾管署發言人羅一鈞表示,國內上一例因克沙奇B5喪命的新生兒死亡個案發生在2015年6月,這是國內時隔10年再現死亡病例,羅一鈞憂心,今年腸病毒還未流行,已累計4例重症,含3例死亡,重症數為5年同期新高,今年夏天恐怕各型別一起大流行。